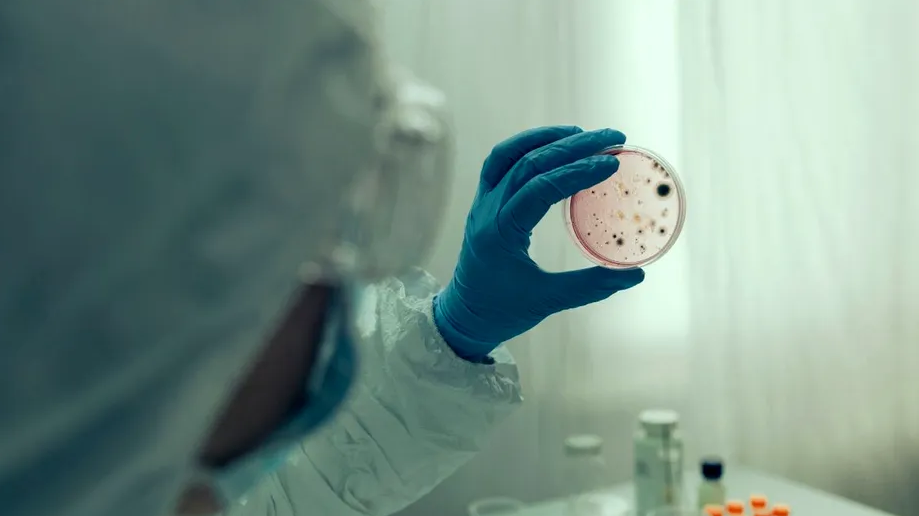

Serratia marcescens este o bacterie Gram-negativă, oportunistă, membră a familiei Yersiniaceae.
Este adesea prezentă în mediul extern — sol, apă, plante — și condiții umede, unde poate coloniza suprafețele.
De asemenea, are capacitatea de a forma biofilme pe suprafața aparaturilor medicale sau tuburilor, ceea ce îi conferă rezistență la tratamentele antimicrobiene și protecție împotriva dezinfectanților.
Istoric, bacteria este cunoscută pentru pigmentul roșu (prodigiosin), dar în mediile clinice acest pigment rar domină, ținând cont de selecția de tulpini adaptate spitalelor.
Tipuri de infecții cauzate și mecanisme de transmitere
S. marcescens poate produce o gamă largă de infecții, mai ales în rândul pacienților vulnerabili — cei internați în spitale, aflați la terapie intensivă, nou-născuți sau cu imunitate scăzută.
Printre tipurile de infecții identificate în literatura medicală se numără:
- infecții ale căilor urinare (mai ales legate de catetere)
- bacteriemie (prezența bacteriei în sânge) și septicemie
- infecții respiratorii (pneumonie)
- infecții ale rănilor, ale sistemului nervos central (meningită) sau infecții nosocomiale ale altor organe
Transmiterea se produce adesea în mediul spitalicesc, prin:
- echipamente medicale contaminate (catetere, tuburi, ventilatoare)
- mâini sau echipamente ale personalului care nu respectă strict igiena
- suprafețe umede, zone de ventilație, sisteme de apă contaminată
Rezistență antibiotică și tratare
Unul dintre cele mai mari pericole asociate cu Serratia marcescens este capacitatea sa de a fi rezistentă la multiple antibiotice.
Studiile arată că multe tulpini nu răspund la penicilină, cefalosporine de primă generație, tetracicline, macrolide și alte clase de antibiotice.
Tratamentul optim implică, de regulă, antibiotice puternice — de exemplu: carbapeneme, aminoglicozide, cefalosporine de generație superioară — și combinații de medicamente, în funcție de testele de sensibilitate.
Totuși, rata mortalității în infecțiile invazive este semnificativă. Într-o analiză a cazurilor medicale, mortalitatea a fost de ~31% în cazuri severe cu S. marcescens.
De ce este grav pentru spitale — relevanță în contextul Iași
Situația de la Spitalul „Sfânta Maria” din Iași capătă gravitate exact pentru că:
- S. marcescens este un agent clinic oportunist și dificil de eliminat din medii spitalicești — este capabil să persistentă și să infecteze infrastructura internă.
- În secțiile de Terapie Intensivă, pacienții sunt deja vulnerabili, cu multiple dispozitive medicale (catetere, tuburi ventilatorii), ceea ce crește riscul de infectare.
- În lipsa măsurilor rapide de izolare, dezinfectare și control, bacteria se poate răspândi cu ușurință între paturi, echipamente și personal medical.
- Diagnosticul și tratamentul întârziate pot duce la complicații severe și la mortalitate ridicată, mai ales la copii.
Ce măsuri trebuie luate — prevenție și control
Pentru a limita riscul și a controla un eventual focar de Serratia marcescens, spitalele trebuie să implementeze:
- protocoale stricte de igienă (spălarea mâinilor, dezinfectarea suprafețelor)
- sterilizarea și monitorizarea echipamentelor medicale
- utilizarea testelor rapide și culturilor pentru identificarea bacteriei în medii și pe aparatură
- izolare timpurie a pacienților infectați
- realizarea testelor de sensibilitate antibiotică pentru a adapta tratamentul
- supraveghere epidemiologică continuă și audituri interne